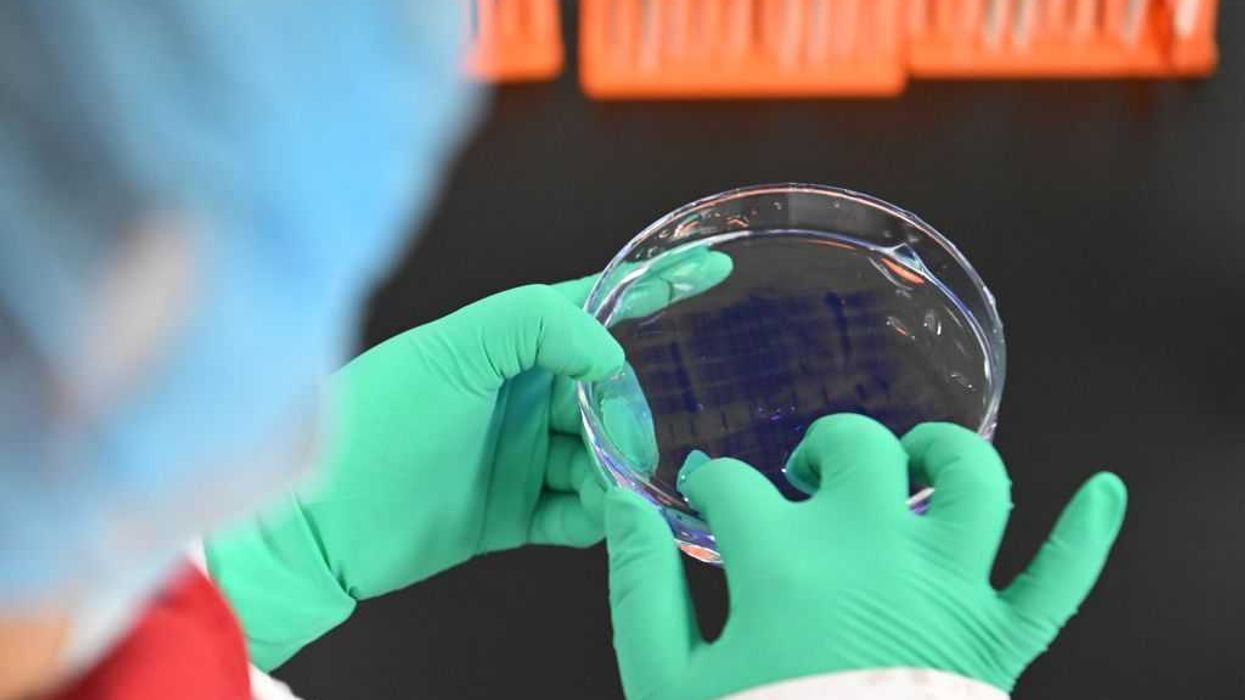

University of Michigan's bio-smuggling scandal explodes: More Chinese scholars busted in alleged plot
More Chinese scholars from the University of Michigan have allegedly been tied to a smuggling conspiracy.
The Select Committee on the Chinese Communist Party announced Wednesday charges against three UM scholars, bringing the total to seven Chinese nationals connected to the alleged smuggling plot.
'It is part of a broader, coordinated campaign targeting universities across the country, driven by China's efforts to acquire American technology.'
In June, the Department of Justice charged Yunqing Jian, 33, and her boyfriend, 34-year-old Zunyong Liu, with smuggling a fungus into the United States. Officials claimed that the Fusarium graminearum could potentially be used as an agricultural terrorism weapon.
Liu allegedly claimed the reason for smuggling the pathogen was to conduct research at UM's laboratory, where Jian worked.
Chengxuan Han, another UM scholar, was also arrested in June after she allegedly mailed several packages containing "biological material related to roundworms" to UM's laboratory.
Han, 28, was sentenced in September to time served and was expected to return to China.
RELATED: University of Michigan now under fire after Chinese scholars allegedly smuggle bio-weapon
Photo by Bill Pugliano/Getty Images
Three additional Chinese nationals who were working at UM were terminated after the U.S. attorney for the Eastern District of Michigan filed new charges, claiming the individuals were involved with a biological material smuggling plot, according to the Select Committee's Wednesday press release.
The Detroit News reported that Xu Bai, 28, Fengfan Zhang, 27, and Zhiyong Zhang, 30, faced charges including smuggling biological material into the country and lying to federal agents.
Han allegedly sent one of the packages to Bai's apartment in Ann Arbor. A complaint reviewed by the Detroit News stated that Bai became uncooperative, refusing to speak with investigators.
Han also allegedly sent several packages to Fengfan Zhang and Zhiyong Zhang.
"When asked if he had ever received any packages from Han, Zhiyong Zhang showed multiple signs of nervous behavior, including his right eye twitching only when discussing Han, and he was unable to fully explain whether he did or did not receive any packages," a federal agent wrote.
UM reportedly fired the three scholars after they refused to cooperate with an internal investigation of the lab, operated by life sciences professor Shawn Xu.
"Professor Xu has been cooperative with the University of Michigan's investigation into the laboratory," Xu's lawyer, David Nacht, told the Detroit News. "He has not been informed by any federal official that he is a target of any investigation."
According to Nacht, the lab continues to operate, and Xu remains in good standing with UM.
"Professor Xu has lived in Michigan for decades, and he does basic biological research on worms," Nacht claimed. "Those present no hazards, nor do they have any military or obvious commercial application."
RELATED: From Wuhan to Michigan: Feds nab ANOTHER Chinese scholar in alleged bio-material smuggling plot
Photographer: Brent Lewin/Bloomberg via Getty Images
In 2019, Zhiyong Zhang allegedly sent a package to Xu that contained petri dishes with nematodes, or roundworms.
"Professor Xu's laboratory routinely receives roundworms and other biological material through the normal mail and [FedEx] and UPS from a laboratory in Minnesota that produces them," Nacht told the Detroit News.
UM's termination of the three scholars means the Chinese nationals are no longer in compliance with their visa requirements and may be subject to deportation.
"These new charges reveal an organized network of scholars engaged in illegal activity on Michigan's campus," Select Committee on China Chairman Rep. John Moolenaar (R-Mich.) stated. "It is part of a broader, coordinated campaign targeting universities across the country, driven by China's efforts to acquire American technology. University leaders should launch internal reviews to safeguard their research from China's adversarial actions. My colleagues and I appreciate the accountability we've seen from Michigan through our oversight efforts, and we will continue to use every tool we have to protect taxpayer-funded research and national security."
Blaze News contacted the Select Committee and the University of Michigan for comment.
Like Blaze News? Bypass the censors, sign up for our newsletters, and get stories like this direct to your inbox. Sign up here!
Originally Published at Daily Wire, Daily Signal, or The Blaze
What's Your Reaction?
Like
0
Dislike
0
Love
0
Funny
0
Angry
0
Sad
0
Wow
0